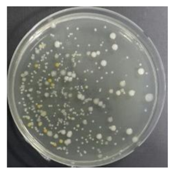
Sustainability 10 01123 i007
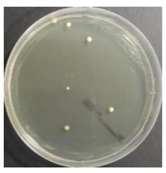
Sustainability 10 01123 i010
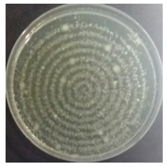
Sustainability 10 01123 i012
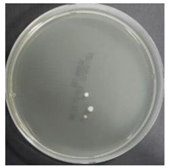
Sustainability 10 01123 i014
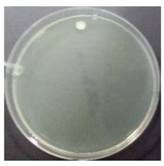
Sustainability 10 01123 i018
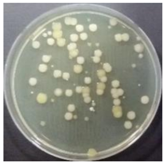
Sustainability 10 01123 i020
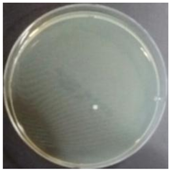
Sustainability 10 01123 i022
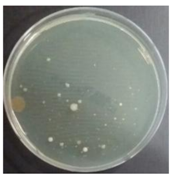
Sustainability 10 01123 i024
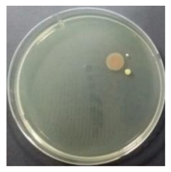
Sustainability 10 01123 i026
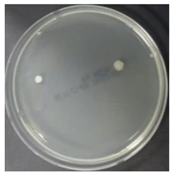
Sustainability 10 01123 i030
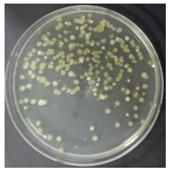
Sustainability 10 01123 i032
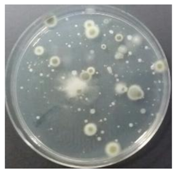
Sustainability 10 01123 i035
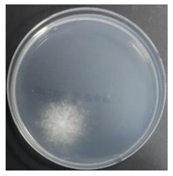
Sustainability 10 01123 i037
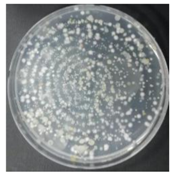
Sustainability 10 01123 i040
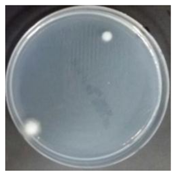
Sustainability 10 01123 i042
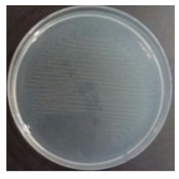
Sustainability 10 01123 i045
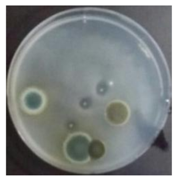
Sustainability 10 01123 i046
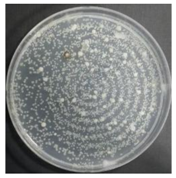
Sustainability 10 01123 i047
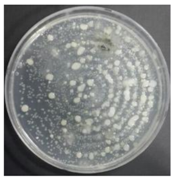
Sustainability 10 01123 i048
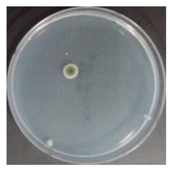
Sustainability 10 01123 i049
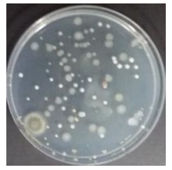
Sustainability 10 01123 i051
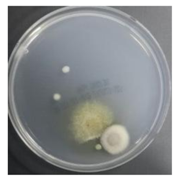
Sustainability 10 01123 i053
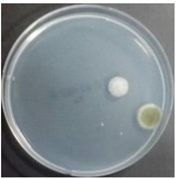
Sustainability 10 01123 i058
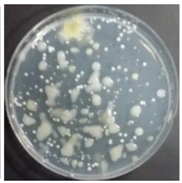
Sustainability 10 01123 i060
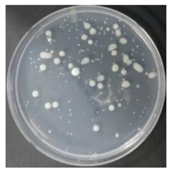
Sustainability 10 01123 i063

1. Introduction
Evaporative cooling technology is a non-vapor compression heating, ventilating, and air conditioning (HVAC) technology that is used as to simultaneously induce the adiabatic cooling of process air with the evaporation of water by performing a heat exchange with water and process air [
1]. Several studies focus on environmentally-friendly technology that cools the air without using refrigerants [
2,
3,
4,
5]. One of these evaporative cooling technologies is an indirect evaporative cooler (IEC), which consists of two channels of plastic material: On the secondary air channel, adiabatically cooled air exchanges sensible heat with process air and on the primary air channel, cools the process air. Another one of these technologies is a direct evaporative cooler (DEC), which is a device that induces adiabatic cooling by passing air through an evaporative cooling pad of wet cellulosic material. Finally, indirect-direct evaporative cooler (IDEC) uses IEC and DEC collectively and is a typical evaporative cooling technology [
6].
A cooling tower and an evaporative condenser form a system that chills cooling water by using evaporative cooling, based on a principle similar to a DEC. It is necessary for the cooling tower, evaporative condenser, and a DEC to provide sufficient water to facilitate adiabatic evaporation. Water is recirculated in most systems to reduce water consumption. However, recirculating water used in cooling towers and evaporative condensers leads to the accumulation of microbial contamination. This type of contamination causes respiratory diseases such as Legionnaires’ disease and may result in casualties [
7,
8,
9].
Legionella bacteria were observed in a dehumidification system by using a lithium chloride solution, according to a principle similar to that of a direct evaporative cooling system [
10].
Legionnaires’ disease occurs when water-borne
Legionella pneumophila bacteria are transferred by aerosols and adhere to the lungs. The functioning of direct evaporative coolers is similar to that of cooling towers and evaporative condensers. However, there has been no known outbreak of Legionnaires’ disease through direct evaporative coolers. This is potentially due to two main reasons. The first is temperature conditions in which it is difficult to activate
Legionella bacteria. Cooling towers and evaporative condensers exhibit higher water temperatures when compared to those in a DEC during operation. Most DECs operate at water temperatures of 20–24 °C.
Legionella bacteria do not multiply in a dormant state at temperatures below 20 °C and are active at 20–45 °C [
11]. Therefore, it is difficult to proliferate
Legionella bacteria in a direct evaporative cooling system (DEC). In areas requiring direct evaporative cooling, the wet bulb temperature is below 25 °C. In DEC, the wet bulb temperature of inlet process air, dry bulb temperature of outlet process air, and temperature of recirculating water are almost equal, thus the DEC is operating at a temperature at which
Legionella does not reproduce [
12].
The second reason is that the droplet size in a direct evaporative cooler is very low. The size of
Legionella is 0.3–0.9 μm wide and 2–20 μm long. For
Legionella to stick to the lungs, it must enter the lungs through droplets with a diameter less than 5 μm (i.e., aerosol). The size of water droplets produced by the direct evaporative cooler differs based on the type of evaporator, however; small water droplet evaporates and the larger is difficult to stick to lungs [
13].
Legionnaires’ disease is unlikely to occur due to the operation temperature range and the droplet sizes in a DEC. However, temperature varies within an annual HVAC system, and other microbes in addition to
Legionella also lead to air pollution [
14].
Several researchers have confirmed that water contamination by microorganisms diffuses into the air and causes pollution in a DECs. Macher and Girman [
15] measured the microbial contamination of a sump, indoor air, and outdoor air when DECs was used, and confirmed a correlation between sump contamination and indoor air quality. Strindehag and Josefsson [
16] compared the bacterial counts of humidified air released from a spray type humidifier and an evaporative humidifier in experiments and simulations that added
Pseudomonas aeruginosa to water. Macher et al. [
17] used tracer bacteria (i.e.,
Micrococcus luteus) to determine the number of microorganisms detected in the discharge air based on the microbial air volume.
The United States Environmental Protection Agency has registered several water biocides to control algae, slime, and bacteria growth in cooling towers, air washers, and evaporative condensers. However, when water biocides are used in DECs, hazardous residual gases and by-products generated by the biocide enter spaces in conjunction with the process air, and this is hazardous to occupants [
6]. Therefore, various methods were examined to solve the problem.
Several studies focused on efforts to prevent contamination of DEC outlet air. Kang and Kato [
18] experimented with microwave disinfection of elements in an evaporative humidifier (EH) by using
Legionella’s germicidal effect temperature characteristics (it is difficult for
Legionella to survive at temperatures exceeding 60 °C). The EH pad was heated to 60 °C for 12 min without a blower and water spray. However, the results confirmed that temperature distribution was irregular, irrespective of wetness, and was not suitable for disinfecting an EH pad. Sung et al. [
19] experimented with UV lamps and a water filter to suppress microbial growth of EH. The results confirmed that the microorganisms on the surface of the element, microorganisms inside the air handling unit (AHU), and pollutants in the recirculating water were significantly reduced when an ultraviolet sterilizer was used, although the internal microorganisms of the element were not removed. It is also difficult to disinfect an EH pad surface by using a UV lamp or a microwave. Additionally, degradation may occur after a certain period of time and cause defects in the equipment.
UV reactors are specifically used to treat drinking water, wastewater, industrial process water, and ballast water by exposing flowing water to the light of a UV lamp, thus inactivating the microorganisms in water. There is no residual effect, and chemicals are not added once the water leaves the UV reactor [
20]. Yamamoto et al. [
21] confirmed the killing rate of
Legionella, based on a dose of UV light when a UV sterilizer generating a wave length of 254 nm was used. The results of the experiments confirmed that a UV sterilizer could be used to control
Legionella in a cooling tower.
In this study, the experiments confirmed that the microbial contamination of a DECs improved when the disinfected water was supplied to the direct evaporative cooling system using a UV reactor.
4. Discussion
Puckorius et al. [
13] reported that
Legionella spp. is difficult to cultivate or transfer because of the system temperature and size of water droplets in a direct evaporative cooling system. However, Macher and Girman [
15] and Strindehag et al. [
16] have confirmed several microbial contaminations of outlet air due to microbial contamination of recirculating water in a direct evaporative cooling system.
4.1. Impact of UV Light
Sung et al. [
19] proposed a germicidal system, installing a UV lamp upstream and downstream of the evaporative humidifier (EH) pad and applying a UV water filter to the circulating water. When the proposed germicidal system was used, the bacteria and fungi decreased significantly on the EH pad surface. Microbial contamination of the circulating water was also reduced. In the case of airborne microbes in the air handling unit, it was confirmed that the bacteria decreased significantly, but the fungi maintained a constant degree of contamination. In a study by Sung et al., microbial contamination of outlet air was not measured. However, the proposed germicidal system improved the air quality of the outlet air when contamination of the outlet air was deduced from the pollution degree of the suspended microorganisms measured in the AHU.
4.2. Impact of UV Reactor
The germicidal system proposed by Sung et al. [
19] improved the internal air in the EH system. The germicidal system consisted of two components, a UV lamp that disinfected the pad surface and air, and a UV water filter which disinfected recirculating water. Therefore, it is unclear what the cause of air quality improvement of outlet air in the AHU was. In this study, two cases were tested based on the assumption that water pollution affects air quality through analysis of previous research (Control and UV-treated). The results of the study are as follows.
In the absence of a UV reactor in the direct evaporative cooling system (Control), bacterial concentrations in the recirculated water showed high concentrations (820,000–1,570,000 CFU/mL) in the AC film. In the direct evaporative cooling system with ultraviolet disinfection (UV-treated), the recirculated water had a low contamination level (100–700 CFU/mL) immediately after disinfection. However, after the disinfected water passed through the evaporative cooling pad, it was confirmed that the contamination increased (1000–340,000 CFU/mL). This suggests that bacteria accumulated in the evaporative cooling pad and pipe, increasing the contamination of recirculating water.
In both groups (Control and UV-treated), no correlation was found between the surface contamination of the sampled microorganisms and the duration of direct evaporative cooling. However, it was confirmed that the fungi were more sensitive to the ultraviolet ray reactor than the bacteria. In both cases, the contamination of bacterial and fungal surfaces was more severe in the outlet sides (outlet and upside outlet) of the four positions. It is predicted that the flow of process air will move the microorganisms in the evaporative cooling pad.
The pollution degree of outlet air of the direct evaporative cooling system increased in proportion to the operation time of the system, and both bacteria and fungi decreased more significantly in the UV-treated than in the Control samples. Through this, it was confirmed that the pollution degree of recirculated water influences the air quality in DEC.
Airborne microbes showed better air quality improvement in this study when compared to the results of Sung et al. [
19]. Surface-borne microbes also showed a more pronounced improvement when compared to the results of Sung et al. [
19].
5. Conclusions
The study empirically evaluated the improvement of microbial air qualityo on a direct evaporation cooling system. Experiments were performed for four weeks, and each divided into a control group (Control case corresponding to DEC that did not recycle water by bypassing the ultraviolet reactor) and experimental groups (UV-treated cases corresponding to DEC that involved recycled water treatment through an ultraviolet reactor). Water, surface, and air microorganisms were sampled twice a week a total of eight times.
In UV-treated cases, the bacterial concentration in the disinfected recirculating water increased after passing through the direct evaporative cooling pad. This indicates that circulating water is contaminated by surface bacteria contaminants in the evaporative cooling pad.
It was difficult to correlate the degree of bacterial and fungal contamination or type of microorganism on the surface of the direct evaporative cooling pad, given the duration of operation. However, the results confirmed that bacterial and fungal contamination were always higher on the outlet side when compared to that at the inlet side in all experimental periods.
A comparison of the air quality in Control and UV-treated cases indicated that airborne bacteria and fungi decreased when the water treatment was subjected to a UV reactor. The results confirmed that the air quality of the direct evaporative cooling system discharge air improved when the quality of recirculated water improved.
Therefore, the contamination of recirculated water in a direct cooling system affects air pollution. Water treatment techniques, such as ultraviolet water treatment systems, are also necessary for continuous water quality improvement in direct cooling systems.